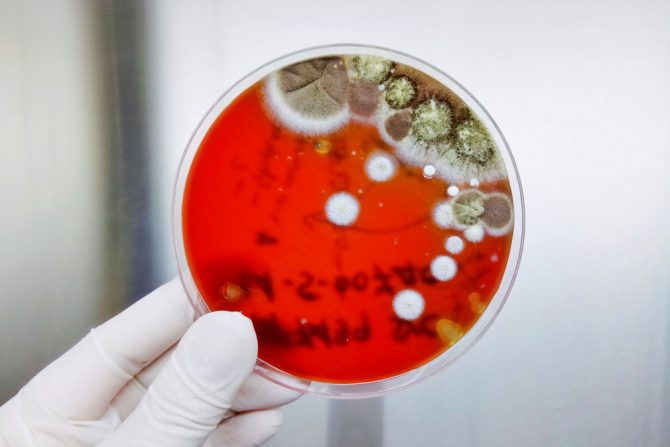
krvav ispljuvak

Krvav ispljuvak – odakle potiče krv u sluzi i na koji problem ukazuje
Krv u sluzi nakon iskašljavanja može da se javi zbog nekih lakših respiratornih problema, ali ako se pojavi zajedno sa komadićima hrane, savet je da se potraži hitna medicinska pomoć
Krvav ispljuvak ili krv u sputumu ili sluzi, koji se javlja kada se iskašljemo ili ispljunemo sluz naziva se hemoptiza. Iako izgleda strašno, ova pojava obično nije razlog za zabrinutost, posebno kod mladih ili zdravih ljudi. Krv u sputumu najčešće se javlja kod mnogih blagih respiratornih stanja, u slučaju infekcije gornjih disajnih puteva, bronhitisa i astme. Može da bude alarmantno ako se iskašlje značajna količina krvi u sputumu ili se krv često vidi u sluzi, i u tim teškim slučajevima, može da bude posledica stanja pluća ili želuca.
Šta može da uzrokuje krvav ispljuvak?
Niz faktora može da dovede do pojave krvi u sputumu, a krv može da potiče iz različitih delova tela. Obično dolazi iz pluća, ali ređe može doći iz želuca ili digestivnog trakta. Ako krv dolazi iz digestivnog trakta, medicinski termin je hematemeza. U slučaju da je poreklo krvi iz pluća reč je o hemoptizi. Ako je krv jarkocrvena, penasta i ponekad pomešana sa sluzi, verovatno dolazi iz pluća i može biti posledica upornog kašlja ili infekcije pluća. Ako je krv tamna i pojavljuje se sa tragovima hrane, verovatno dolazi iz stomaka ili negde drugde iz digestivnog trakta, što se smatra ozbiljnijim stanjem.
Mogući uzroci krvi u sputumu su:
- Bronhitis. Hronični bronhitis je često razlog pojave krvi. Stanje podrazumeva upornu ili ponavljajuću upalu disajnih puteva, uz kašalj i proizvodnju šlajma.
- Bronhiektazije. Ovo stanje opisuje se kao trajno proširenje delova disajnih puteva pluća. Često se javlja uz infekciju, kratak dah i piskanje.
- Produžen ili jak kašalj. Može da iritira gornje disajne puteve i pokida krvne sudove.
- Ozbiljno krvarenje iz nosa. Mnogi faktori mogu izazvati krvarenje iz nosa.
- Upotreba droga. Droge, kao što je kokain, koje se udišu kroz nozdrve mogu iritirati gornje disajne puteve.
- Antikoagulansi. Ovi lekovi sprečavaju zgrušavanje krvi, kao na primer, warfarin, rivaroxaban, dabigatran i apixaban.
- Hronična opstruktivna bolest pluća (HOBP). HOBP je trajna opstrukcija protoka vazduha iz pluća. Obično uzrokuje otežano disanje, kašalj, proizvodnju sputuma i piskanje.
- Upala pluća. Ova i druge infekcije pluća mogu da izazovu krvavi sputum. Pneumoniju karakteriše zapaljenje plućnog tkiva, obično zbog bakterijske infekcije. Ljudi sa pneumonijom osećaju bol u grudima pri disanju ili kašljanju, umor, temperaturu, pojačano znojenje ili im je mnogo hladno. Starije odrasle osobe takođe mogu doživeti konfuziju.
- Plućna embolija. Stanje koje se odnosi na stvaranje krvnog ugruška u jednoj arteriji pluća. Obično izaziva bol u grudima i iznenadni kratak dah.
- Edem pluća. Pojava stvaranja tečnosti u plućima. Edem pluća je najčešći kod ljudi sa srčanim oboljenjima. Izaziva ružičasti i penasti sputum, kao i jako otežano disanje, ponekad sa bolom u grudima.
- Rak pluća. Veća je verovatnoća da osoba ima rak pluća ako je starija od 40 godina i pušač je. Karcinom može da izazove kašalj koji ne nestaje, kratak dah, bol u grudima, a ponekad i bol u kostima ili glavobolju.
- Rak vrata. Obično počinje u grlu, larinksu ili dušniku. Može izazvati otok ili ranu koja ne zaceljuje, trajnu upalu grla i crvenu ili belu fleku u ustima.
- Cistična fibroza. Ovo nasledno stanje ozbiljno oštećuje pluća. Obično izaziva otežano disanje i uporan kašalj sa gustim šlajmom.
- Granulomatoza sa poliangiitisom. Reč je o zapaljenje krvnih sudova u sinusima, plućima i bubrezima. Obično izaziva curenje iz nosa, krvarenje iz nosa, kratak dah, piskanje i temperaturu.
- Tuberkuloza. Bakterija izaziva ovu tešku infekciju pluća, koja može dovesti do groznice, znojenja, bolova u grudima, bolova pri disanju i upornog kašlja.
- Suženi srčani zalisci. Suženje srčanog mitralnog zaliska, nazvano stenoza mitralnog zaliska, može izazvati kratak dah, posebno pri naporu ili kada čovek leži. Ostali simptomi su otečena stopala ili noge i lupanje srca ili umor, posebno kod povećane fizičke aktivnosti.
- Teška povreda. Trauma grudnog koša može da izazove pojavu krvi u sputumu.
Kada treba otići kod lekara?
Na lekarski pregled treba otići kada posle kašlja u ispljuvku ima mnogo krvi ili ako se krv javlja u čestim intervalima. Ako je krv tamna i pojavljuje se sa komadićima hrane, savet je da se odmah potraži hitna pomoć jer to ukazuje na ozbiljan problem koji potiče iz digestivnog trakta.
Takođe, lekara treba posetiti i ako bilo koji od sledećih simptoma prati krv u sputumu:
- gubitak apetita
- neobjašnjivi gubitak težine
- krv u urinu ili stolici
- bol u grudima, groznica ili vrtoglavica
- pogoršanje kratkog daha.
Kako se postavlja dijagnoza ako neko ima krvav ispljuvak?
Kako bi utvrdio da li zdravstveno stanje uzrokuje krvav ispljuvak, lekar obično uzima anamnezu i obavlja fizički pregled. Tokom pregleda, lekar može da zatraži da se pacijent zakašlje, proveravaju nos i usta na mestu krvarenja. Lekar takođe može uzeti uzorke sputuma i krvi za testiranje. U nekim slučajevima su neophodni dodatni pregledi kao što su rendgenski snimak grudnog koša, CT skeniranje ili bronhoskopija.
Kako se leči pojava krvi u sputumu?
Tretmani imaju za cilj zaustavljanje krvarenja i lečenje osnovnog uzroka. Mogući tretmani su:
Steroidi - pomažu kada je zapaljensko stanje uzrok krvarenja
Antibiotici - koriste se u slučajevima pneumonije ili tuberkuloze
Bronhoskopija - omogućava detaljan pregled mogućih izvora krvarenja. Instrument koji se zove endoskop ubacuje se u disajne puteve kroz nos ili usta. Alati se mogu pričvrstiti na kraj. Neki su dizajnirani da zaustave krvarenje, dok drugi, na primer, mogu ukloniti krvni ugrušak.
Embolizacija - Ako je glavni krvni sud odgovoran za krv u sputumu, lekar može preporučiti proceduru koja se zove embolizacija. U sud se ubacuje kateter, identifikuje se izvor krvarenja i koristi se metalni kalem, hemikalija ili fragment želatinskog sunđera da se zatvori.
Transfuzija krvnih produkata - Transfuzija elemenata u krvi, kao što su plazma, faktori zgrušavanja ili trombociti, može da bude potrebna ako su problemi sa zgrušavanjem ili preterano retka krv odgovorni za pojavu krvi u sputumu.
Hemoterapija ili radioterapija - Tretmani za lečenje raka pluća.
Hirurgija - Primenjuje se za uklanjanje oštećenog ili kanceroznog dela pluća. Operacija se obično smatra poslednjim sredstvom za rešavanje problema kod upornog krvarenja.
eKlinika zadržava sva prava nad sadržajem. Za preuzimanje sadržaja pogledajte uputstva na stranici Uslovi korišćenja.


Avdic Refik
Ujutro mi se pojavila zgrusana krv u ustima.Sta je razlog i kako odnosno odakle dolazi.Puno vam hvala za odgovor.
Podelite komentar